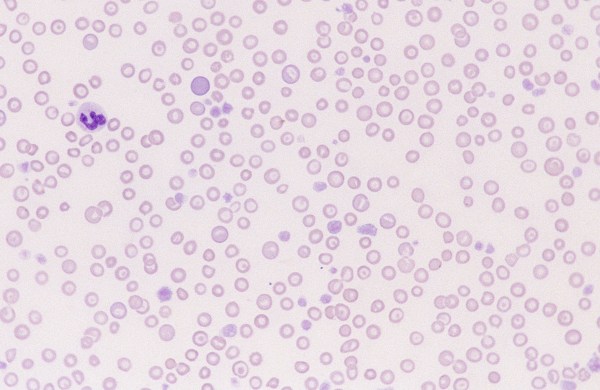
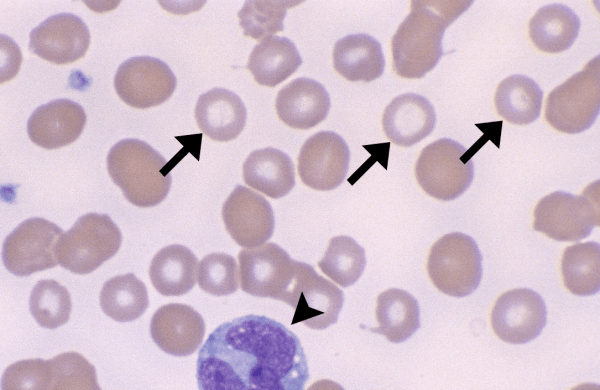
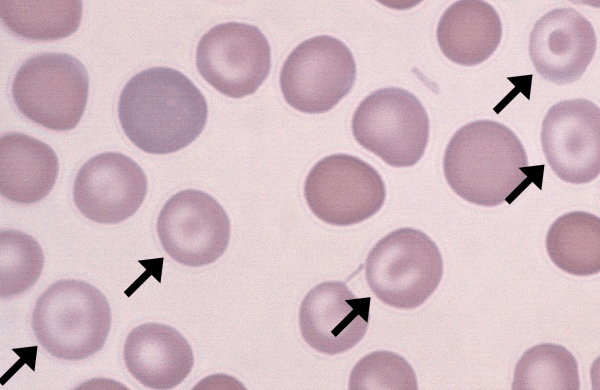

Morphology: red blood cells that stain very pale due to loss of hemoglobin through intravascular lysis. Commonly seen with: other features of immune-mediated hemolytic anemia (IMHA) including spherocytes, polychromatophils, and agglutination… Read more Ghost Cells →

Morphology: red blood cells that stain pain with increased central pallor and thin rim of hemoglobin (decreased hemoglobin content). Look alike: torocytes (increased central pallor with normal thick rim of hemoglobin). Commonly… Read more Hypochromasia →

Morphology: red blood cells with increased central pallor and a normal thick rim of hemoglobin creating a “punched out” appearance. Look alikes: codocytes (bullseye), hypochromasia (increased central pallor with thin rim of… Read more Torocytes →

Also called: target cells Morphology: canine red blood cells with a bullseye appearance. Caused by increased ratio of cell membrane to hemoglobin content which results in a central bulge. Look alike:… Read more Codocytes →

Morphology: immature red blood cells that stain blue with new-methylene blue due to precipitation of retained cytoplasmic RNA. Aggregate reticulocytes are less mature with large amounts of RNA that form dark… Read more Reticulocytes →

Morphology: immature red blood cells that stain dark purple on Romanowsky stains (Wright’s, Diff-Quick) due to retained cytoplasmic RNA. Larger than normal red cells. Commonly seen with: features of regenerative anemia (macrocytosis,… Read more Polychromatophils →